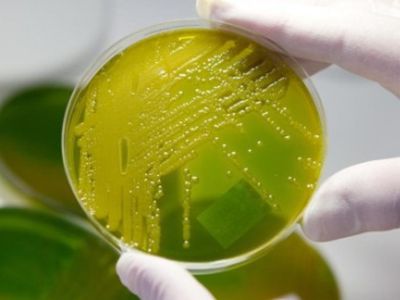
Mirtinas E. coli protrūkis Vokietijoje baigėsi - Pasaulyje

Что не удаётся мэру Висагинаса? Дороги, или как мэр Висагинаса латал дороги
Загрузка...
--

Необычное происшествие произошло недавно в квартире одной из жительниц города

Повтор на канале ТТС интеллектуальной игры, посвященной 1150-летию государственности России, смотрите сегодня, 29 июля в 21.00 ч.

В американском штате Южная Каролина вступил в силу новый закон, позволяющий небольшим перегонным заводам производить самогон

Приближение августа вызывает у экономистов нервную дрожь

Литва завоевала свободу, когда рушилась советская империи, не только благодаря собственным усилиям, но и благодаря уникальным изменениям в сознании людей ...

В четверг, 28 июля, администрация самоуправления в лице ее директора, руководителей некоторых отделов и специалистов встретилась с представителями висагинских общественных организаций



Italijoje savo namuose Turino mieste mirė kavos karaliumi vadinamas Emilio Lavazza

Pasak Aplinkos ministerijos ir Vilniaus savivaldybės, atliekų rūšiavimo gamykla Vilniuje turėtų pradėti veikti jau 2013 metais.

Белорусская милиция задержала телефонного хулигана, угрожавшего в четверг, 28 июля, взорвать Центральный железнодорожный вокзал в Минске

26 июля в ДТП трагически погиб легендарный оператор Эдуард Розовский, который снял такие фильмы, как «Белое солнце пустыни», «Три мушкетера», ...

Президент Литвы Даля Грибаускайте сегодня, 29 июля, в день 20-летия с момента подписания договора о принципах межгосударственных взаимоотношений между Литвой ...

Власти города Мурсия на юго-востоке Испании начали уникальную кампанию по привлечению пассажиров в общественный транспорт

Исследователи из Великобритании сделали выводы, что после тридцати лет садиться на диеты уже бессмысленно

Уральские инноваторы придумали универсальный бортовой сенсорный датчик UniBoS

Beveik po dviejų mėnesių tyliųjų protestų, baltarusiai trečiadienį pirmą kartą nesusirinko į nurodytas vietas.

Nekilnojamojo turto pardavėjai pastebi, kad po krizės bundant būsto rinkai, pirkėjai vis daugiau dėmesio kreipia į gyvenamosios vietos aplinką.

Po išpuolio Norvegijoje kai kurios Europos šalys, svarsto galimybę sugriežtinti prekybą trąšomis.

Чудо-чудное, диво-дивное! Висагинские «богатыри» снова удивляют горожан своей «силищей»

По данным директора консульского департамента МИД Литвы Витаутаса Пинкуса, в первом полугодии 2011 года жителям Белоруссии выдано на 59% больше ...

Отказ от атомной энергетики и кардинальная перестройка системы энергообеспечения обойдется Германии в 335 миллиардов евро, сообщает Welt со ссылкой на ...

Швейцарский франк набирает популярность среди инвесторов как одна из наиболее надежных валют, особенно на фоне долгового кризиса в Европе и ...

Как выяснилось, двухметровая рептилия принадлежит пляжному фотографу, который делал снимки отдыхающих с земноводным.

Dalyje Pietų Afrikos Respublikos antradienį iškritęs sniegas bei šaltis sukėlė transporto chaosą, teko uždaryti didžiausius greitkelius ir geležinkelių linijas.


Китайская пара не знала, что нарушает закон

Обзор СМИ Литвы за неделю
